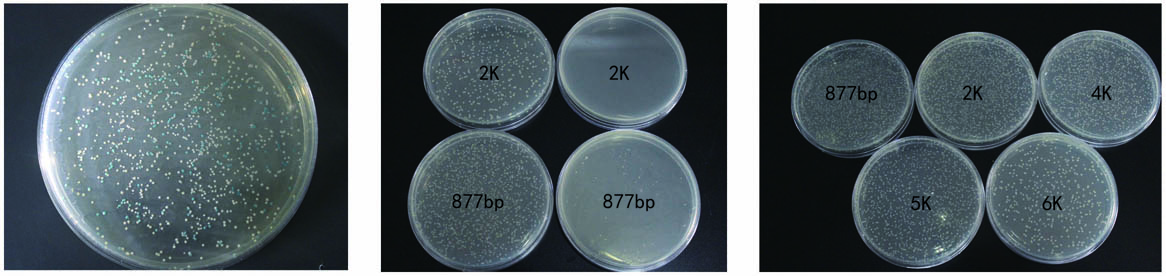

產品優惠|快速克隆解決方案之載體篇——5折促銷!!!
發布者:莊盟生物發布時間:2017-05-26瀏覽次數:3694次
快速克隆解決方案——載體篇
快速:室溫5分鐘快速連接
高效:重組率極高,長斑數多
陽性率高:2K以下片段陽性率>90%,可連接低至5ng/μl片段;成功連接長達12Kb片段
零背景:采用自殺基因篩選技術無需藍白斑篩選
| 節省約1.5小時 | ||||
| 傳統 | 傳統 | 本公司 | 本公司 | |
| PCR片段 | 質粒 | PCR片段 | 質粒 | |
| 連接 | 5min/過夜 | 5min | ||
| 冰浴 | 30min | 30min | 5min | 1min |
| 熱擊 | 30-90S | 30-90S | 60S | |
| 冰浴 | 2min | 2min | 2min | |
| 復蘇 | 60min | 60min | ||
| 時間 | 1小時38分鐘 | 1小時33分鐘 | 13分鐘 | 1分鐘 |
| 注:僅限于Amp抗性載體 | ||||
貨號 | 名稱 | 規格 | 目錄價 | 促銷價 | 截止日期 |
ZC204-1 | pBLUE-T快速克隆試劑盒 (含多克隆酶切位點) | 20次 | 420 | 190 | 2017年6月1日 至 2017年10月31日 |
ZC204-2 | 60次 | 1050 | 525 | ||
ZC205-1 | 零背景ZT4-Blunt快速克隆試劑盒 (含多克隆酶切位點) | 20次 | 520 | 260 | |
ZC205-2 | 60次 | 1380 | 690 | ||
ZC208-1 | 零背景ZT4 Simple-Blunt快速克隆試劑盒 (不含多克隆酶切位點) | 20次 | 520 | 260 | |
ZC208-2 | 60次 | 1380 | 690 | ||
ZC206-1 | ZTOPO-TA零背景快速克隆試劑盒 (含多克隆酶切位點) | 20次 | 680 | 340 | |
ZC206-2 | 60次 | 1800 | 900 |
載體陽性率檢測(以下均為連接2K片段) |
![]() |
| 載體名稱:pBLUE-T 載體名稱:ZT4-Blunt 載體名稱:ZT4 Simple-Blunt 載體名稱:ZTOPO-TA |
| 快轉實例(注:以下均為全部菌液) |
![]() |
載體名稱:pBLUE-T 載體名稱:ZT4-Blunt T公司TOPO載體 載體名稱:ZT4-Blunt 片段大小:2K 片段大小:如上圖所示 片段大小:如上圖所示 |